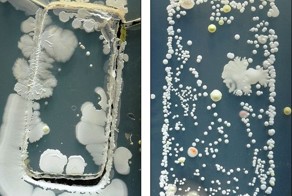

697
20
Гаджеты, интересное, концепты.
Интересный прототип летательного аппарата был представлен на выставке CES 2016 китайским производителем Ehang. Компания не стала распыляться на самые маленькие дроны в мире, её разработка куда интереснее - модель Ehang 184 рассчитана на перевозку одного пассажира с багажом. Таким образом, новинка стала самым большим дроном в мире, являющимся своего рода такси.
×
Автономный летательный аппарат имеет вес 200 кг, 8 электродвигателей, 4 складывающиеся "руки" и 8 пропеллеров, габариты 1447х3866х3899 мм, скорость полёта 100 км/ч и время полёта 23 минуты. В воздух Ehang 184 может поднять груз весом до 100 кг. Внутри транспорта нет ничего, что хоть отдалённо напоминало бы органы управления. Пассажиру предлагается разместить ручную кладь в багажный отсек, поудобнее расположиться в кресле, пристегнуться ремнями безопасности и выбрать пункт назначения на дисплее 12-дюймового планшета, после чего наслаждаться видом из окна или быстрым интернетом. Создание оптимального маршрута, полное и при этом безопасное пилотирование (взлёт, полёт, облёт препятствий, посадка) автономный дрон берёт на себя.
Компания намерена в ближайшем будущем использовать макси-дрон для коммерческой перевозки людей или грузов. По утверждению разработчиков, машина уже в этом году будет доступна для приобретения, а её стоимость составит от $200 000 до $300 000. Остаётся только вопрос - удастся ли Ehang разрешить все нормативно-правовые аспекты и преграды в странах, где намечаются продажи дрона-такси.
Источник:
Ссылки по теме:
- Будущее здесь: 15 крутых гаджетов, которые каждый захочет купить в 2016 году
- Гаджеты, которые в СССР можно было "достать только по блату"
- Какую заразу может вам подарить мобильный телефон
- Полезные вещи, которые сделают ваш рабочий день лучше
- Отличные гаджеты, игры и сайты на рубеже эпох

С учетом массово-инерционных характеристик летательного аппарата, малейший ветерок и нижний пропеллер при посадке встречается с землей, с разрушением всей двигательно движительной установки. Никакая электроника не в состоянии будет отреагировать на мгновенное изменения положения ЛА по крену или тангажу.
Всю эту квадрокоптерную схему нужно размещать сверху, над кабиной, как на обычных вертолетах :)